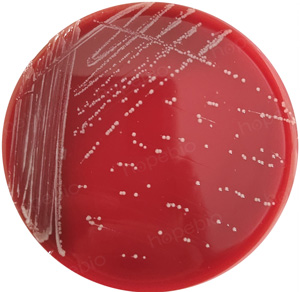

海博微信公众号
海博微信公众号
 海博天猫旗舰店
海博天猫旗舰店


 海博微信公众号
海博微信公众号
 海博天猫旗舰店
海博天猫旗舰店




温度作为影响微生物生长发育的核心环境因子,直接调控微生物细胞内酶的活性、细胞膜的流动性、物质运输效率及遗传物质的稳定性。不同类群的微生物经过长期进化,形成了独特的温度适应性机制,进而呈现出差异显著的最适培养温度。深入研究微生物与其最适培养温度的对应关系,不仅是微生物学基础研究的重要内容,更为工业发酵、环境保护、医疗卫生等领域的技术创新提供关键理论支撑。
微生物对温度的适应性具有严格的范围界限,通常可根据其生长温度范围分为低温微生物(嗜冷菌)、中温微生物(嗜温菌)、高温微生物(嗜热菌)三大类,每类微生物均有其专属的最适培养温度区间。这种分类并非绝对割裂,部分微生物还具有较宽的温度适应范围,被称为兼性嗜冷菌或兼性嗜热菌,但它们仍存在一个生长速率最快、代谢活性最强的最适温度点。最适培养温度的本质,是微生物细胞内各项生理生化反应达到动态平衡的温度条件,此时酶促反应效率最高,细胞分裂与物质合成的速率最快,微生物的生长繁殖状态最佳
一、低温微生物
低温微生物主要生活在常年低温的环境中,如极地冰川、深海海域、高山冻土等,其最适培养温度通常在0℃~15℃之间。根据对低温的适应程度,可进一步分为专性嗜冷菌和兼性嗜冷菌。
专性嗜冷菌如假单胞菌属的某些菌株(如荧光假单胞菌)、冷球菌属、极地弧菌等,其生长温度范围较窄,通常在0℃以下即可生长,最适温度多为10℃~12℃,当温度超过20℃时,细胞内的酶会因空间构象破坏而失活,细胞膜的流动性也会急剧下降,导致微生物无法生长甚至死亡。其中,从南极海域分离的南极冷球菌,最适培养温度仅为8℃,在15℃以上环境中生长完全停滞。
兼性嗜冷菌如乳酸菌(如植物乳杆菌低温菌株)、酵母菌(如假丝酵母)中的部分菌株,其最适培养温度相对较高,多在15℃~20℃之间,在0℃以上的低温环境中可缓慢生长,在常温下也能正常代谢。李斯特菌最适生长温度为30℃~37℃,但能在0℃~45℃范围内存活,在4℃时仍可繁殖,因此是冷藏食品的主要威胁。耶尔森菌最适生长温度为20℃~25℃,最高可达30℃~37℃,能在4℃左右大量繁殖,常见于蔬菜、乳制品和肉类等食品。
低温微生物的适应机制主要包括细胞膜中不饱和脂肪酸含量较高,通过增加不饱和脂肪酸的比例来维持细胞膜在低温下的流动性,确保物质运输的正常进行;同时,其细胞内的酶具有较强的低温活性,酶的结构中含有较多的柔性氨基酸残基,能够在低温环境中保持催化功能。在实际应用中,低温微生物常用于冷藏食品的发酵、低温污水的处理等领域,例如利用嗜冷乳酸菌(如干酪乳杆菌低温株)发酵生产低温酸奶,其最适发酵温度控制在10℃~15℃,可保留酸奶中的营养成分和风味物质;利用低温反硝化菌处理低温市政污水,最适温度12℃~15℃,能有效去除污水中的氮素污染物。
二、中温微生物
中温微生物是自然界中分布最广泛的微生物类群,其生长温度范围为20℃~45℃,最适培养温度多在25℃~37℃之间。这类微生物主要生活在温带、亚热带的土壤、水体、空气以及动植物体内,包括大多数细菌、真菌、放线菌等。根据其宿主环境的不同,中温微生物可分为腐生型和寄生型。
腐生型中温微生物如枯草芽孢杆菌、大肠埃希氏菌(K12菌株)、黑曲霉、米曲霉等,最适培养温度多为25℃~30℃,广泛存在于土壤和水体中,参与自然界的物质循环,如枯草芽孢杆菌在28℃~30℃的条件下生长旺盛,可产生淀粉酶、蛋白酶等多种酶类,常用于工业酶制剂的生产;米曲霉最适培养温度28℃,是生产酱油、豆腐乳的核心发酵菌株。
寄生型中温微生物如结核分枝杆菌、金黄色葡萄球菌、肺炎链球菌、流感病毒等,其最适培养温度与宿主的体温相近,多为35℃~37℃,能够在宿主体内快速生长繁殖,引发疾病。例如,金黄色葡萄球菌最适培养温度37℃,在人体皮肤黏膜表面大量增殖时,可引发毛囊炎、蜂窝织炎等感染性疾病;结核分枝杆菌最适培养温度36℃,在肺部组织中定植生长,导致肺结核。
中温微生物的温度适应机制较为简单,其细胞膜中不饱和脂肪酸与饱和脂肪酸的比例适中,能够在常温下维持稳定的流动性;细胞内的酶具有中等温度活性,在25℃~37℃的范围内催化效率最高。由于中温微生物的最适培养温度接近室温,培养条件相对容易控制,因此在工业发酵、生物医药、环境治理等领域应用最为广泛,例如利用大肠埃希氏菌在37℃的条件下发酵生产胰岛素,利用黑曲霉在28℃~30℃的条件下生产柠檬酸,利用产黄青霉在25℃~28℃条件下生产青霉素等。
三、高温微生物
高温微生物主要生活在高温环境中,如火山口、热泉、深海热液口等,其生长温度范围为45℃~80℃以上,最适培养温度多在55℃~75℃之间。根据生长温度的上限,可分为专性嗜热菌和极端嗜热菌。
专性嗜热菌如芽孢杆菌属的某些高温菌株(如嗜热脂肪芽孢杆菌)、放线菌中的链霉菌属部分菌株(如高温链霉菌),最适培养温度为55℃~65℃,生长温度上限可达70℃~80℃。其中,嗜热脂肪芽孢杆菌最适培养温度56℃~60℃,常用于食品工业的热力灭菌效果验证。
极端嗜热菌如古菌中的热球菌属(如激烈热球菌)、硫化叶菌属(如嗜酸热硫化叶菌)等,最适培养温度高达70℃~85℃,部分菌株甚至可以在100℃以上的高温环境中生长,如从深海热液口分离的热液古菌,最适培养温度为95℃,在121℃的高压条件下仍可存活。
高温微生物的适应机制具有独特性,其细胞膜中含有大量的饱和脂肪酸和分支脂肪酸,部分极端嗜热菌的细胞膜甚至由特殊的脂质组成,能够在高温下保持细胞膜的稳定性和完整性;细胞内的酶具有极强的热稳定性,酶的结构中含有较多的二硫键和疏水相互作用,能够在高温环境中维持空间构象的稳定,同时其DNA中含有较多的GC碱基对,GC碱基对之间的氢键数量较多,可增强DNA的热稳定性。
高温微生物在工业生产中具有重要的应用价值,例如利用高温淀粉酶产生菌(如地衣芽孢杆菌高温菌株)在60℃~65℃的条件下生产高温淀粉酶,该酶可用于纺织、造纸、食品加工等领域,具有耐高温、稳定性强等优点;利用极端嗜热菌生产的DNA聚合酶(如Taq酶,源自水生栖热菌,最适反应温度72℃),广泛应用于PCR技术中;利用嗜热菌产生的木聚糖酶在70℃条件下处理造纸浆料,可有效降低浆料黏度,提高纸张质量。
除了上述三大类微生物外,还有一类特殊的微生物被称为嗜常温菌,其最适培养温度与人类生活环境的温度相近,多在20℃~25℃之间,如大多数酵母菌(如酿酒酵母)、霉菌(如毛霉、根霉)等,常用于食品发酵、酿酒等行业。例如,酿酒酵母最适培养温度22℃~25℃,是白酒、啤酒、葡萄酒发酵的核心菌株,在该温度下能高效产生乙醇;毛霉最适培养温度20℃~23℃,常用于腐乳的发酵制作。
此外,部分微生物的最适培养温度还会受到其他环境因子的影响,如pH值、氧气含量、营养物质浓度等。例如,在有氧条件下,大肠埃希氏菌的最适培养温度为37℃,而在无氧条件下,其最适培养温度会降至30℃左右;当培养基中营养物质浓度较低时,某些细菌如荧光假单胞菌的最适培养温度会略有升高,以加快代谢速率来获取足够的营养物质。在微需氧条件下,空肠弯曲菌在42℃±1℃条件下生长良好,如图1,在微需氧条件下25℃±1℃及有氧条件下42℃±1℃培养后均不生长,如图2。
图1 空肠弯曲菌 ATCC 33291哥伦比亚血琼脂平板微需氧条件下42℃±1℃培养结果

图2 空肠弯曲菌 ATCC 33291哥伦比亚血琼脂平板上的培养结果
注:左为微需氧条件下25℃±1℃培养,右为有氧条件下42℃±1℃培养
微生物的温度适应性与最适培养温度是其长期适应自然环境的进化成果,深刻反映了生命与环境的协同共生关系。从极地冰川的低温微生物到深海热液口的极端嗜热菌,从广泛分布的中温微生物到适配人类生活环境的嗜常温菌,不同类群微生物凭借独特的生理机制,在各自的温度生态位中实现高效生长与代谢。这些机制不仅保障了微生物自身的生存繁衍,更为人类利用微生物资源提供了丰富的可能性,无论是工业发酵中的酶制剂生产、食品加工中的风味调控,还是环境保护中的污水净化、生物医药中的药物合成,精准把握微生物的最适培养温度及环境影响因素,都是提升技术效率与产品质量的关键。未来,随着对微生物温度适应机制研究的不断深入,尤其是在极端环境微生物资源的开发、温度调控与其他环境因子的协同作用等方面的探索,必将为更多领域的创新突破注入新的动力,让微生物资源在服务人类社会发展中发挥更大的价值。
相关产品:
注:本文属海博生物原创,未经允许不得转载。
下一篇:嗜肺军团菌的生化试验和结果判读
| 相关文章: | ||



